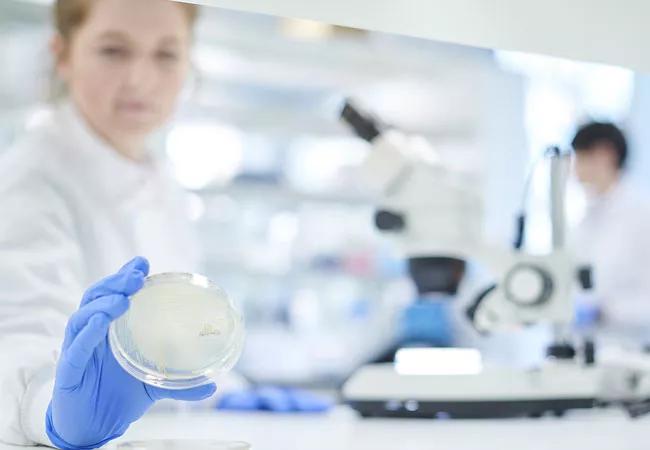

Study finds increasing prevalence of article retraction in Ob/Gyn research in the last decade
Image content: This image is available to view online.
View image online (https://assets.clevelandclinic.org/transform/5b826869-f877-4664-8d92-cf08c8951181/19-OBG-1149-Hero_CQD_650x450_929854906_jpg)
19-OBG-1149-Hero_CQD_650x450_929854906
Plagiarism and data falsification are widespread within Ob/Gyn research, with retracted articles coming from over 90 journals and from all subspecialties, according to a new article in the British Journal of Obstetrics and Gynecology.
Advertisement
Cleveland Clinic is a non-profit academic medical center. Advertising on our site helps support our mission. We do not endorse non-Cleveland Clinic products or services. Policy
“One of the consequences of research misconduct is article retraction. In recent years, there has been a significant increase in the number of articles retracted from the literature after publication. We designed this study to understand trends and reasons for article retraction, specifically in the obstetrics and gynecology literature,” states Laura Chambers, DO, a fellow in Cleveland Clinic’s division of Gynecologic Oncology. “We found that article retraction is a significant problem in gynecology research.”
In a retrospective review of articles listed in the PubMed database in June 2018, Cleveland Clinic researchers identified all articles in Ob/Gyn and subspecialties. A total of 173 articles were retracted from 93 journals for research misconduct, which includes plagiarism, data falsification, unethical research practices or conflicts of interest. Importantly, over three-quarters of the retracted articles were retracted in the last decade. Most articles were retracted for content-related reasons, including plagiarism (22.7%), errors in data (21%), or falsified data (14.8%). Only 2.3% of retracted articles were later republished.
Of the retracted articles, 49.4% were clinical studies (n = 87) and 38% were basic science research (n = 67). By subspecialty, 43.2% of retractions were in gynecologic oncology (n = 76), 20.5% were in gynecology (n = 36), 17.6% were in obstetrics (n = 31) and 9.1% were infertility and reproductive endocrinology (n = 16).
The median time to retraction was about two years from publication, during which time clinical decisions were being made, and other research may have been conducted based on the falsified or erroneous conclusions.
Advertisement
“There are two findings that we feel are very important. First, article retractions have increased over recent years. Specifically, 86% of retracted articles have been published since 2000, and 77% of the articles were retracted within the last decade. Therefore, either scientific misconduct leading to research retractions is a growing problem in obstetrics and gynecology research, or we are becoming more aware of the issue.,” Dr. Chambers says. “Second, we identified that despite retraction, articles are still being re-cited in the literature. The median number of citations of a retracted article is eight, demonstrating how retracted articles are being wrongfully propagated despite efforts to remove these articles from the medical literature.”
There were 176 first authors listed for these retracted papers, and 18 of them had more than two retracted papers. Importantly, one first author had 10 retracted papers. Among the 166 senior authors listed for the retracted papers, nine of them published two or more papers that were eventually retracted. One senior author had nine retractions, and one had 10 retractions. The median H-index factor for senior authors with retracted articles was 19.0; thus, article retraction does not appear to be the result of inexperience. The median journal impact factor of the retracted articles was 2.5.
“There are severe consequences, on a variety of levels, to publishing false data or plagiarizing in research,” says Chad Michener, MD, interim chair of Cleveland Clinic’s Department of Subspecialty Care for Women’s Health and Associate Professor of Surgery for the Cleveland Clinic Lerner College of Medicine of Case Western University. “For the individual, publishing unreliable or unethical research can lead to article retraction, which may have significant consequences for an author’s academic and clinical career, including loss of funding and/or employment. On a larger scale, disseminating findings that may not be generalizable can impact patient care and future scientific discovery.”
Advertisement
Most academic medical centers have safeguards, such as Institutional Review Boards, in place to prevent research malpractice. Providing additional training on research best practices, such as data storage compliance and plagiarism prevention software, may help ensure the lasting publication of quality research.
Advertisement
Advertisement
Counseling and careful surgical considerations are key
Deprivation is linked to impaired glucose intolerance and racial disparities
Perioperative prophylaxis and class III obesity
Artesunate ointment is safe well and tolerated patients with vulvar intraepithelial neoplasia
Endoscopic balloon dilation during pregnancy helps optimize outcomes
Researchers examine waste and implore colleagues to take action
Mode of delivery does not affect patient satisfaction